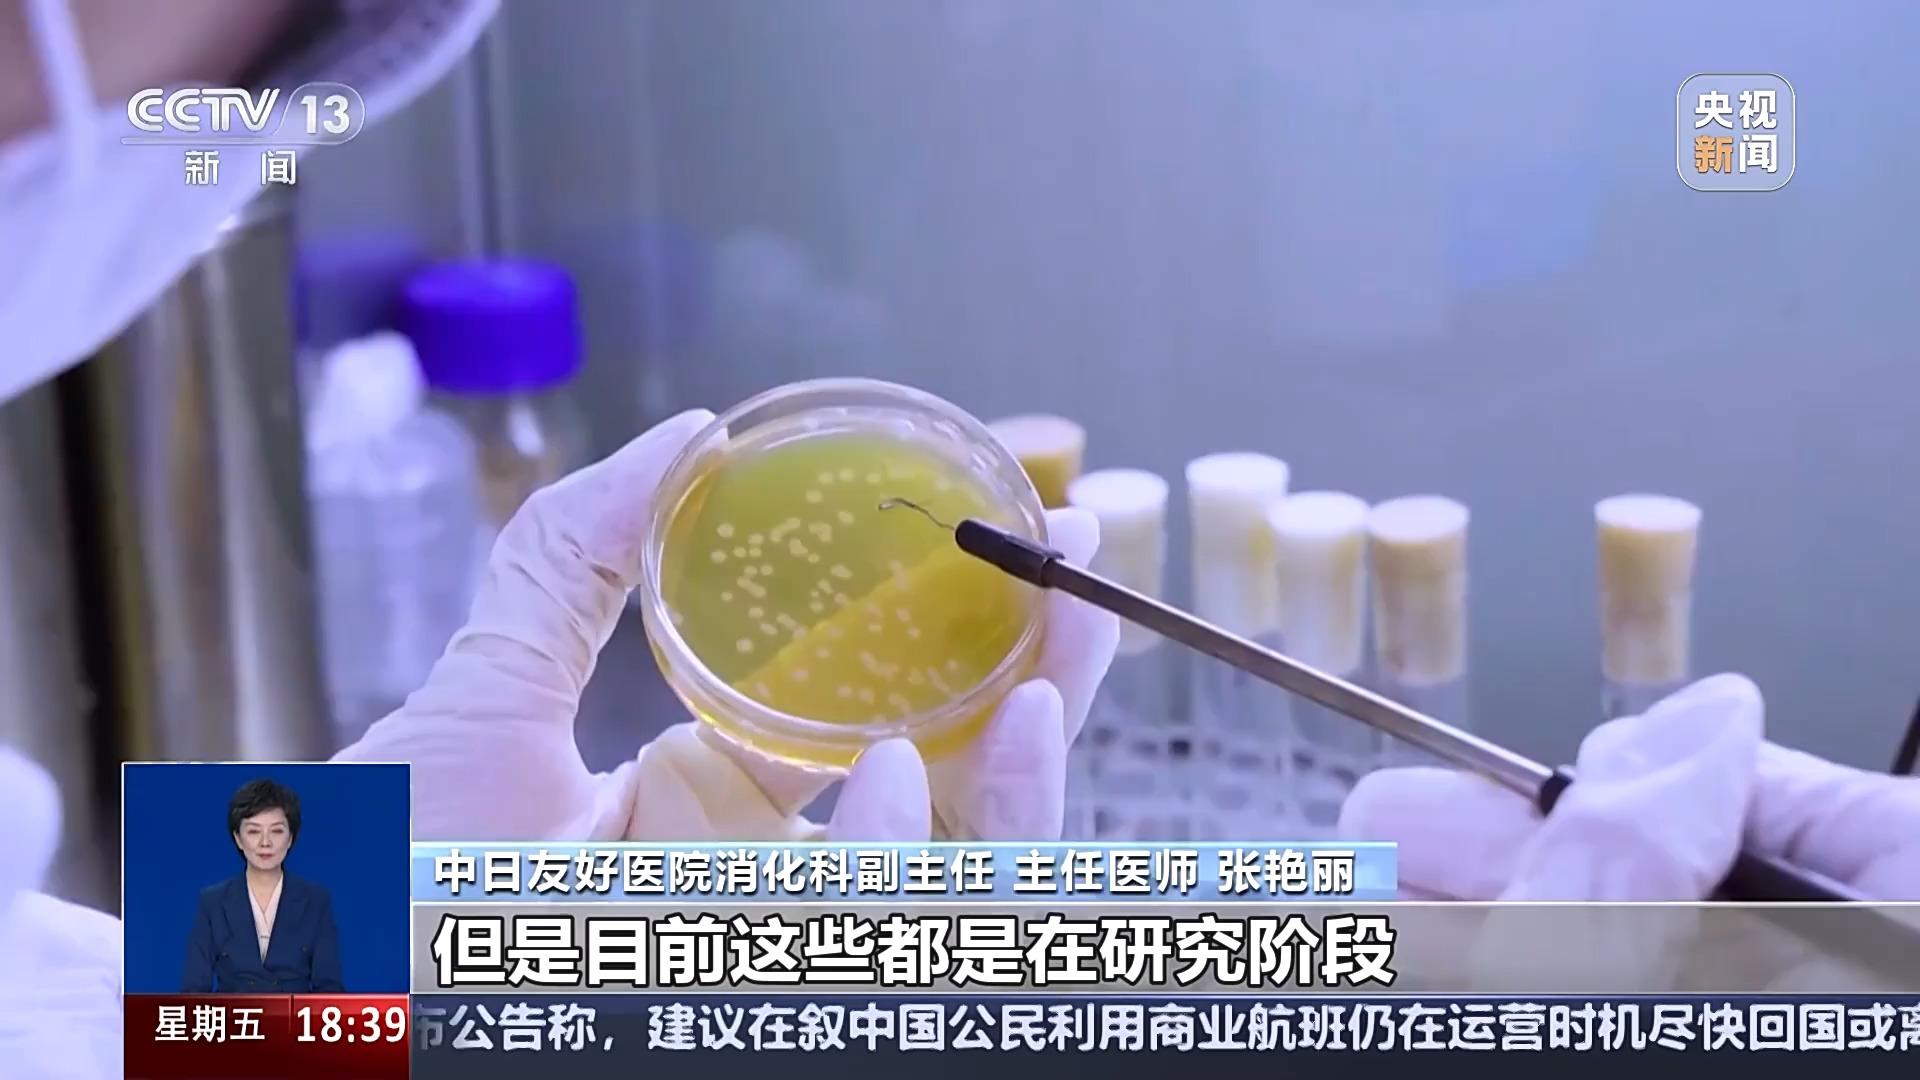

在如今这个快节奏的时代,肠胃问题经常不请自来,是不是也曾困扰着您呢?有时候胃胀、胃痛、消化不良都让人吃不消,于是很多人就把希望寄托在了益生菌身上。
随着近些年来网络直播带货的兴起,在直播平台上,有关于益生菌产品的直播非常多,不少带货人现身说法,吸引了网友购买。在这些宣传中,益生菌产品和添加了益生菌的食品甚至是生活用品被赋予了各种各样的功效。
您是不是也曾经稀里糊涂跟风买过,又对它的功效似懂非懂呢?今天我们就来说说益生菌到底“神奇在哪儿”。
网络平台直播带货益生菌产品种类繁多
这几年,益生菌的所谓神奇功效,被不少带货直播间“夸张夸大”,带货主播从开播、产品介绍、 促单到售后、回购等等一套“声情并茂”的话术下来,不少网友就这样被“说”动心了。

益生菌不是包治百病的“万金油”
在这些商家的宣传中,益生菌俨然成了包治百病的健康万金油,不仅能减肥、改善厌食、治疗过敏、妇科病,甚至是抗癌、抗衰老等。益生菌的作用真的有这么神奇吗?我们首先要来了解一下什么是益生菌。2001年,联合国粮农组织和世界卫生组织联合专家委员会提出了益生菌的科学定义:益生菌系指活的微生物,当摄取足够数量时,对宿主健康有益。

目前,这一概念已被全世界广泛使用。简单来说,益生菌就是对人体有益的活菌。也就是说,益生菌想要发挥作用,必须达到有特定功能的菌株、有足够量的活菌到达肠胃、对人体产生明确的健康好处。益生菌种类繁多,迄今为止,已发现的常用益生菌大体可分成乳杆菌类,比如嗜酸乳杆菌;双歧杆菌类,比如长双歧杆菌、短双歧杆菌等;链球菌类,比如唾液链球菌等,以及其他类,如酵母菌、丙酸杆菌等。

根据国家卫生健康委发布的相关标准和规定,目前我国可用于食品的菌种,有17个属38个种或亚种,可用于婴幼儿食品的菌种有14个株,且仅限用于1岁以上幼儿。
吃益生菌能减肥、能改善厌食、能治过敏?
在益生菌产品的宣传中,提到最多的是这么几个功效,一个是能改善肠道功能从而达到减肥的目的、一个是能治疗儿童厌食,第三个甚至说能治疗过敏,那么益生菌到底有没有这些功效呢?
中日友好医院消化科副主任 主任医师 张艳丽:从目前临床的循证医学证据来看的话,没有说益生菌能够直接减重和增加饱腹、抑制食欲的作用,但是益生菌作为一个对宿主健康有益的活性的微生物,它在减重的过程中可能会起到一些辅助的作用。但是目前这些都是在研究阶段,而且都是限定在一些特定的菌株,这些研究的结果其实并不一定都是很肯定的,所以我们要作为一个全面的认识,而肥胖作为一个系统,其实减重是一个系统的工程,那么我们首先要通过一个健康的饮食,适度的运动,这种干预作为首选。

至于网络直播中宣称的不需做任何运动,只靠吃益生菌,就可以减重,专家对此也做了回应。

中日友好医院消化科副主任 主任医师 张艳丽:从科学上讲是讲不通的,首先在这么短的时间内,没有摄入的减少,没有消耗的增加,单纯几天的益生菌达到一个明显的减重肯定是不可信的。

对于益生菌改善儿童厌食的问题,专家表示并不是所有的厌食都是因为肠道菌群紊乱导致,即使是这个原因也要在医生的指导下补充益生菌。

首都儿科研究所副所长,细菌学研究室主任 袁静:厌食挑食,其实它跟多种因素相关,益生菌可能会对它起到一个调节的作用,这个完全能够治疗,我觉得这个也是缺乏一些科学依据的。

而对于益生菌是否能治疗过敏,专家表示,过敏是一个非常复杂的机体免疫紊乱问题,涉及遗传、环境、个体免疫状态等多种因素,目前一些研究显示,确实某些特定益生菌对过敏治疗有辅助作用,但根治过敏是没有依据的。

中日友好医院消化科副主任 主任医师 张艳丽:比如说它可能通过调整肠道菌群的平衡,减少机体对过敏的这种免疫反应,甚至也有研究会发现某一些特定的益生菌,它可能对于过敏以后这种比较严重的炎症反应也起到一个抑制的作用,从而改善患者过敏的症状,或者是改善一下他的生活状态,这些是有帮助的。但是这些很多都是在研究阶段的,很多研究的结果也不一致,并且没有一个公认的某一个菌株对哪一类的过敏有效果,甚至也有研究都显示它对过敏症完全没有效。
有关益生菌 这几个误区你“踩雷”了吗?
除了这些所谓的包治百病的“功效”,关于益生菌,其实我们有不少常见的误区。

刚才我们提到了:
第一个误区:益生菌可以包治百病。目前的科学研究表明,益生菌虽然对某些疾病有一定的辅助治疗作用,但并不能替代药物治疗。益生菌主要是通过调节肠道菌群平衡,增强人体免疫力等方式来促进健康,对于一些严重的疾病,还需要依靠药物治疗。

第二个误区:所有的益生菌都差不多。实际上,不同的益生菌菌株具有不同的功效和作用机制。例如,双歧杆菌可以到达大肠,促进肠蠕动,帮助排便;嗜热链球菌可以进入小肠,帮助人体消化乳糖等。消费者应该按需选择。

第三个误区:益生菌可以长期服用。这一点要提醒您,虽然益生菌对健康有很多好处,但并不适合长期服用。长期服用益生菌可能会导致肠道菌群的依赖性,降低肠道自身的调节能力。具体服用时间,最好在医生或专业人士的指导下进行。

第四个误区:益生菌补充是多多益善。我们经常在益生菌产品上,看见CFU标记。益生菌的CFU单位是用来表示益生菌活菌数量的一个指标。它指的是在一定条件下,益生菌在样品中形成的菌落数量。商家对于益生菌的宣传动辄含有8000亿(CFU)、1万亿(CFU)的数量,先不论拿到消费者手中真正还有多少活菌,单就益生菌本身而言,并不是补充越多越好。
人体菌群保持平衡 益生菌并非多多益善

中日友好医院消化科副主任 主任医师 张艳丽:益生菌虽然我们说是对肠道有益的菌,但是过量服用的时候也会有一些不良反应或者副作用。
首先我们说大量的这种活性的微生物进入体内,进入我们消化道,有可能首先引起一些消化道的症状,比如有些人出现腹胀,排气多,甚至出现便秘、腹泻或者一些消化不良的症状,导致他的肠道菌群更加紊乱,这是最常见的。
其次的话这种大量的活性的益生菌,它可能会作为一个病原,那么对于免疫功能机体状态不好的情况下,它可能反倒会诱发感染,一个肠源性的感染,出现一些感染的症状。

专家提示,人体菌群应该保持在平衡状态,因此益生菌并不是越多越好,过度摄入和补充益生菌不仅不能对人体产生积极作用,还有可能导致人体脏器负荷过重,产生严重的负面作用,从而严重扰乱肠道环境。
合理膳食结构才是均衡肠道菌群的关键
最后我们也提醒您,饮食才是影响肠道菌群构成的主要因素之一,不要盲目相信益生菌的作用。合理的膳食结构,才是对人体保持均衡肠道菌群的关键,而抽烟饮酒、吃腌制食品都可能会对肠道菌群产生“杀伤力”。与其补充益生菌产品,不如多吃些富含益生菌的天然食品。同时,多锻炼,增加户外活动,自然地调整才是补充益生菌最科学的方式。